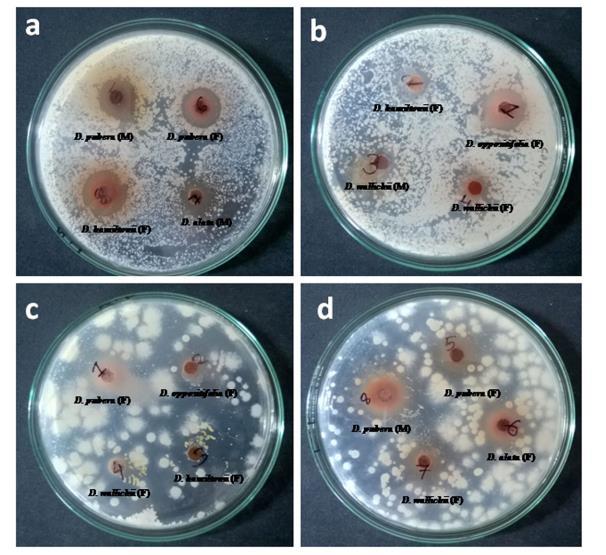

ĐÁNH GIÁ CHẤT LƯỢNG CỦA DƯỢC LIỆU HOÀI SƠN (Dioscorea hamiltonii Hook.f.), HỌ CỦ NÂU (Dioscoreaceae) TRỒNG TẠI NHO QUAN, NINH BÌNH WORD VERSION | 2023 EDITION ORDER NOW / CHUYỂN GIAO QUA EMAIL TAILIEUCHUANTHAMKHAO@GMAIL.COM ĐÁNH GIÁ CHẤT LƯỢNG CỦA DƯỢC LIỆU Ths Nguyễn Thanh Tú eBook Collection Hỗ trợ trực tuyến Fb www.facebook.com/DayKemQuyNhon Mobi/Zalo 0905779594 vectorstock com/24597468 Tài liệu chuẩn tham khảo Phát triển kênh bởi Ths Nguyễn Thanh Tú Đơn vị tài trợ / phát hành / chia sẻ học thuật : Nguyen Thanh Tu Group
DẠYKÈMQUYNHƠN OFFICIALBỘ GIÁO DỤC VÀ ĐÀO TẠO BỘ QUỐC PHÒNG HỌC VIỆN QUÂN Y TẠ THU HÀ ĐÁNH GIÁ CHẤT LƯỢNG CỦA DƯỢC LIỆU HOÀI SƠN (Dioscorea hamiltonii Hook.f.), HỌ CỦ NÂU (Dioscoreaceae) TRỒNG TẠI NHO QUAN, NINH BÌNH KHÓA LUẬN TỐT NGHIỆP DƯỢC SỸ ĐẠI HỌC HÀ NỘI 2022
DẠYKÈMQUYNHƠN OFFICIALBỘ GIÁO DỤC VÀ ĐÀO TẠO BỘ QUỐC PHÒNG HỌC VIỆN QUÂN Y TẠ THU HÀ ĐÁNH GIÁ CHẤT LƯỢNG CỦA DƯỢC LIỆU HOÀI SƠN (Dioscorea hamiltonii Hook.f.), HỌ CỦ NÂU (Dioscoreaceae) TRỒNG TẠI NHO QUAN, NINH BÌNH KHÓA LUẬN TỐT NGHIỆP DƯỢC SỸ ĐẠI HỌC Cán bộ hướng dẫn: ThS. Nguyễn Văn Liệu HÀ NỘI 2022
c tập tại trường. Em cũng xin gửi lời cảm ơn chân thành nhất tới các thầy cô giáo và các kĩ thuật viên của Bộ môn Dược liệu - Dược học cổ truyền nói riêng cũng như toàn thể các thầy cô giáo và các kĩ thuật viên của Viện Đào tạo Dược, Học viện Quân Y đã luôn chỉ dạ
DẠYKÈMQUYNHƠN OFFICIALLỜI CẢM ƠN Trong quá trình thực hiện khóa luận, với sự nỗ lực, cố gắng của bản thân và sự giúp tận tình của các thầy cô, gia đình và bạn bè để em đã có thể hoàn thành khóa luận này một cách tốt nhất. Đầu tiên, em xin được bày tỏ lòng biết ơn và gửi lời cảm ơn chân thành nhất đến ThS. Nguyễn Văn Liệu, người thầy trực tiếp hướng dẫn, tận tình chỉ dạy và tạo mọi điều kiện giúp đỡ em trong suốt quá trình nghiên cứu và thực hiện khóa luận này. Em xin gửi lời cảm ơn tới Ban Giám đốc Học viện Quân Y, Viện Đào tạo Dược đã tạo mọi điều kiện thuận lợi cho em trong suốt 5 năm họ
y tận tình và tạo mọi điều kiện giúp đỡ em trong suốt quá trình học tập và nghiên cứu. Cuối cùng, em xin gửi lời cảm ơn tới gia đình, người thân và bạn bè, những người đã luôn ở bên, động viên và giúp đỡ em vượt qua những khó khăn trong quá trình thực hiện khóa luận này. Em xin chân thành cảm ơn! Hà Nội, ngày12 tháng07 năm2022 Sinh viên Tạ Thu Hà
DẠYKÈMQUYNHƠN OFFICIALMỤC LỤC LỜI CẢM ƠN................................................................................................ 3 DANH MỤC CÁC BẢNG 8 DANH MỤC CÁC HÌNH.............................................................................. 9 DANH MỤC CÁC KÝ HIỆU VÀ CHỮ VIẾT TẮT.................................... 11 DANH MỤC PHỤ LỤC .............................................................................. 13 ĐẶT VẤN ĐỀ ............................................................................................... 1 CHƯƠNG 1 TỔNG QUAN......................................................................... 2 1.1. VỊ TRÍ PHÂN LOẠI CÂY HOÀI SƠN ..............................................2 1.2. ĐẶC ĐIỂM THỰC VẬT CÂY HOÀI SƠN........................................3 1.3. PHÂN BỐ VÀ SINH THÁI ................................................................4 1.4. THÀNH PHẦN HÓA HỌC.................................................................4 1.4.1. Allantoin....................................................................................... 4 1.4.2. Acid amin..................................................................................... 5 1.4.3. Polyphenol.................................................................................... 7 1.4.4. Phenanthren.................................................................................. 9 1.4.5. Saponin......................................................................................... 9 1.4.6. Các hợp chất khác....................................................................... 10 1.4. TÁC DỤNG SINH HỌC...................................................................11 1.4.1. Tác dụng kháng khuẩn và kháng nấm......................................... 11
1.4.2. Tác
1.4.3. Tác
1.4.4.
2.1.1. Nguyên
2.1.2. Dung môi,
2.1.3. Trang thi
DẠYKÈMQUYNHƠN OFFICIAL
dụng chống oxy hóa............................................................. 14
dụng hạ đường huyết............................................................ 16
Một số tác dụng sinh học khác.................................................... 18 1.5. TÁC DỤNG VÀ CÔNG DỤNG THEO Y HỌC CỔ TRUYỀN........19 CHƯƠNG 2 - NGUYÊN VẬT LIỆU VÀ PHƯƠNG PHÁP NGHIÊN CỨU............................................................................................................. 21 2.1. NGUYÊN VẬT LIỆU NGHIÊN CỨU..............................................21
liệu ................................................................................ 21
hóa chất, thuốc thử.................................................... 21
ết bị và dụng cụ nghiên cứu.......................................... 22 2.2. PHƯƠNG PHÁP NGHIÊN CỨU......................................................23 2.2.1. Phương pháp mô tả..................................................................... 23 2.2.2. Phương pháp soi bột ................................................................... 23 2.2.3. Phương pháp định tính................................................................ 23 2.2.4. Phương pháp xác định độ ẩm...................................................... 24 2.2.5. Phương pháp xác định tro toàn phần........................................... 25 2.2.6. Phương pháp xác định tạp chất ................................................... 25 2.2.7. Phương pháp xác định các chất chiết được trong dược liệu......... 26 2.2.8. Phương pháp định lượng allantoin bằng sắc ký lỏng hiệu năng cao 27 2.3. XỬ LÝ KẾT QUẢ 30 2.4. ĐỊA ĐIỂM THỰC HIỆN ..................................................................30
DẠYKÈMQUYNHƠN OFFICIALCHƯƠNG 3 - KẾT QUẢ NGHIÊN CỨU VÀ BÀN LUẬN........................ 31 3.1. KẾT QUẢ MÔ TẢ............................................................................31 3.2. KẾT QUẢ SOI BỘT .........................................................................32 3.3. KẾT QUẢ ĐỊNH TÍNH ....................................................................32 3.3.1. Hiện tượng huỳnh quang............................................................. 32 3.3.2. Sắc ký lớp mỏng......................................................................... 33 3.4. KẾT QUẢ XÁC ĐỊNH ĐỘ ẨM........................................................34 3.5. KẾT QUẢ TRO TOÀN PHẦN.........................................................34 3.6. KẾT QUẢ XÁC ĐỊNH TẠP CHẤT..................................................35 3.6.1. Dược liệu có màu vàng và đỏ...................................................... 35 3.6.2. Tạp chất...................................................................................... 35 3.7. KẾT QUẢ XÁC ĐỊNH CÁC CHẤT CHIẾT ĐƯỢC TRONG DƯỢC LIỆU........................................................................................................35 3.7.1. Chất chiết được trong nước......................................................... 35 3.7.2. Chất chiết được trong cồn........................................................... 36 3.8. KẾT QUẢ ĐỊNH LƯỢNG ALLANTOIN BẰNG SẮC KÝ LỎNG HIỆU NĂNG CAO ..................................................................................37 3.8.1. Kết quả thẩm định phương pháp định lượng 37 3.8.2. Kết quả định lượng allantoin trong Hoài sơn 42 KẾT LUẬN 44 KIẾN NGHỊ................................................................................................. 46
DẠYKÈMQUYNHƠN OFFICIALTÀI LIỆU THAM KHẢO............................................................................ 47 PHỤ LỤC .................................................................................................... 50
DANH MỤC CÁC BẢNG
STT Tên bảng
Trang
1.1 CTCT của một số acid amin phân tích được trong củ Hoài sơn 5
1.2 Hoạt động kháng khuẩn của dịch chiết củ đực và củ cái loài D. hamiltonii được thu hái ở Tripura (Ấn Độ) 12
1.3 Hoạt tính kháng khuẩn của dịch chiết D. hamiltonii 13
1.4 Kết quả đo lượng đường máu trong chuột thử nghiệm 1 17
1.5 Kết quả đo lượng đường máu trong chuột thử nghiệm 2 17
1.6 Tác dụng gây độc tế bào của củ Hoài sơn thu hái tại Vĩnh Phúc 19
2.1 Các dung môi, hóa chất, thuốc thử dùng trong nghiên c
Các thi
nghiên
DẠYKÈMQUYNHƠN OFFICIAL
ứu 21 2.2
ết bị, dụng cụ
cứu 22 3.1 Rf và màu sắc của các vết trên sắc ký đồ mẫu dịch chiết đối chiếu và dịch chiết thử bột Hoài sơn 33 3.2 Độ ẩm của rễ củ Hoài sơn 34 3.3 Tro toàn phần của rễ củ Hoài sơn 34 3.4 Tạp chất trong rễ củ Hoài sơn 35 3.5 Chất chiết được trong rễ củ Hoài sơn bằng nước 36 3.6 Chất chiết được trong rễ củ Hoài sơn bằng cồn 36 3.7 Kết quả khảo sát tính tương thích hệ thống sắc ký 37 3.8 Sự tương quan giữa diện tích pic và nồng độ allantoin 40 3.9 Kết quả khảo sát độ lặp lại 42 3.10 Kết quả định lượng allantoin trong rễ củ Hoài sơn 43
STT
DANH MỤC CÁC HÌNH
Tên hình
Trang
1.1 Ảnh vẽ cây Hoài sơn D. hamiltonii Hook.f. 3
1.2 CTCT của allantoin phân lập được từ Hoài sơn 4
1.3 CTCT của cyclo (phenylalanin tyrosin) phân lập được từ Hoài sơn 7
1.4 CTCT của một số hợp chất polyphenol phân lập được từ cây Hoài sơn 8
1.5 CTCT của một số hợp chất phenanthren phân lập được từ thân rễ Hoài sơn 9
1.6 CTCT của một số hợ
Hoài
1.7 CTCT
1.8
DẠYKÈMQUYNHƠN OFFICIAL
p chất saponin phân lập được từ
sơn 10
của 1-monolinolenin phân lập được từ củ Hoài sơn 11
Hoạt động kháng khuẩn của củ đực và củ cái của một số loài thuộc chi Dioscorea 12 1.9 Biểu đồ thể hiện giá trị IC50 về khả năng thu dọn gốc tự do của dịch chiết methanol loài D. hamiltonii với mẫu đối chứng (acid ascorbic, trolox và quercetin) 15 3.1 Ảnh chụp củ tươi (1a) và rễ củ Hoài sơn đã cắt lát, sấy khô (1b) 31 3.2 Ảnh chụp đặc điểm bột rễ củ Hoài sơn 32 3.3 Ảnh chụp bột Hoài sơn soi dưới ánh sáng tử ngoại ở bước sóng 366 nm 32 3.4 Ảnh chụp các vết trên bản mỏng sắc ký mẫu dịch chiết đối chiếu và dịch chiết thử bột Hoài sơn 33
DẠYKÈMQUYNHƠN OFFICIAL3.5 Sắc ký đồ mẫu trắng 38 3.6 Sắc ký đồ dung dịch chuẩn allantoin nồng độ 12,5 µg/ml 39 3.7 Sắc ký đồ dung dịch thử 39 3.8 Đồ thị biểu diễn sự phụ thuộc tuyến tính giữa nồng độ và diện tích pic của allantoin 41
DẠYKÈMQUYNHƠN OFFICIALDANH MỤC CÁC KÝ HIỆU VÀ CHỮ VIẾT TẮT TT Viết tắt Viết đầy đủ 1. ABTS 2,2' azino bis (aicd 3 ethylbenzothiazoline 6 sulfonic) 2. CHCl3 Chloroform 3. CH3OH Methanol 4. CTCT Công thức cấu tạo 5. DĐVN Dược điển Việt Nam 6. D. persimilis Dioscorea persimilis 7. D. hamilitonii Dioscorea hamiltonii 8. DPPH 2,2 - diphenyl - 1 - picryhydrazyl 9. IC50 Inhibitory Concenration 50% (Nồng độ ức chế 50%) 10. FRAP Ferric Reducing Antioxidant Power (Khả năng chống oxy hóa bằng phương pháp khử sắt) 11. HPLC High performance liquid chromatography (Sắc ký lỏng hiệu năng cao) 12. LD50 Lethal Dose, 50% (Liều gây chết 50%) 13. P Probability value (Giá trị xác suất) 14. RSD Relative Standard Deviation (Độ lệch chuẩn tương đối) 15. SD Standard deviation (Độ lệch chuẩn)
DẠYKÈMQUYNHƠN OFFICIAL16. TT Thuốc thử 17. UV Ultraviolet (Tia tử ngoại) 18. X Giá trị trung bình
DANH MỤC PHỤ LỤC
DẠYKÈMQUYNHƠN OFFICIAL
PHỤ LỤC 1 Kết quả giám định tên khoa học
T V
Việt Nam. Trong nhân dân, ngoài sử dụng để làm lương thực thì cây Hoài sơn còn được biết đến với những công dụng như: bổ tỳ, dưỡng vị, sinh tân, ích phế, bổ thận và chỉ khái. Ngoài ra, những nghiên cứu quốc tế được công bố cũng chứng minh các tác dụng sinh học của loài cây này gồm: tác dụng độc tế bào, chống oxy hóa, điều hòa miễn dịch, hạ đường huyết,… Những kết quả trên đã cho thấy các giá trị y học tiềm năng của cây Hoài sơn. Mặc dù vậy, dược liệu Hoài Sơn phần lớn đang được nhập khẩu từ nước ngoài. Để tự chủ nguồn nguyên
DẠYKÈMQUYNHƠN OFFICIAL 1 ĐẶ
ẤN ĐỀ Ngày nay, nhu cầu sử dụng các sản phẩm có nguồn gốc thiên nhiên đang ngàycàngtăngcao. Việt Nam là một trong nhữngquốc gia có nguồntài nguyên động thực vật làm thuốc vô cùng phong phú và đa dạng, tạo cơ hội thuận lợi cho phát triển của ngành dược liệu. Do đó, việc tìm kiếm, bảo tồn và phát triển các loài dược liệu chứa những hoạt tính sinh học có ứng dụng tốt trong chăm sóc sức khỏe và điều trị bệnh đang là một xu hướng thu hút được sự quan tâm nhiều nhà khoa học và doanh nghiệp Cây Hoài sơn (Dioscorea hamiltonii Hook.f.) thường được gọi là cây Củ mài, là một loài dây leo phổ biến, phân bố rộng khắp các vùng rừng núi ở
liệu làm thuốc và bảo tồn nguồn gen của loại dược liệu này thì việc trồng và chăm bón cây thuốc là yêu cầu cần thiết. Tuy nhiên, để đảm bảo chất lượng của dược liệu trồng được cần phải tiến hành kiểm nghiệm và có những đánh giá khoa học. Do vậy, chúng em thực hiện đề tài “Đánh giá chất lượng của dược liệu Hoài sơn (Dioscorea hamiltonii Hook.f.), họ Củ nâu (Dioscoreaceae) trồng tại Nho Quan, Ninh Bình” với mục tiêu: Đánh giá được chất lượng của dược liệu Hoài Sơn trồng tại Văn Phương, Nho Quan, Ninh Bình.
1.1. VỊ TRÍ PHÂN LOẠI CÂY HOÀI SƠN
Cây Hoài sơn có tên khoa học là Dioscorea hamiltonii Hook.f., họ Củ nâu: Discoreaceae.
Tên khác: Dioscorea persimilis Prain & Burk.
Tên tiếng Việt: Hoài sơn, Củ mài, Khoai mài, Khoai sơn, Sơn dược, Từ Hamilton, Chính hoài, Mằn chèn, Mán dịn, Co mằn kép, Mắn ôn, Hìa dòi, Gờ lờn.
Tên nước ngoài:
Yam, Mountain yam (tiếng Anh).
Murmujja, Amiala, Brara, Thakan budo, Tan Pawa, Tha Lang Ta (tiếng Bangladesh).
Guan Shan Yao, He Bao Shu Yu, Yuan Bian Zhong (tiếng Trung Quốc).
Igname (tiếng Pháp).
Naagar kanda, Moodavenni, Sandikilangu, Thalikkizhangu, Merumtua Sanga, Palru, Piska Sanga, Sika Kanda, Suta Alu (tiếng Ấn Độ) [1].
C
DẠYKÈMQUYNHƠN OFFICIAL 2 CHƯƠNG 1 - TỔNG QUAN
ây Hoài sơn có vị trí phân loại như sau: Giới Thực vật (Plantae) Ngành: Ngọc lan (Magnoliophyta) Lớp: Hành (Liliopsida) Phân lớp: Hành (Liliidae) Bộ: Củ nâu (Dioscoreales) Họ: Củ nâu (Dioscoreaceae) Chi: Dioscorea [2].

DẠYKÈMQUYNHƠN OFFICIAL 3 1.2. ĐẶC ĐIỂM THỰC VẬT CÂY HOÀI SƠN Dây leo có 1 2 rễ củ mập hình trụ hơi dẹt, thuôn dần về phía đầu như hình quả bầu, dài 30 - 50 cm, có thể đến 1 m, ăn sâu xuống đất. Thân cây nhẵn, hơi có cạnh, đôi khi có màu đỏ, thường mang những củ ngắn, nhỏ ở kẽ lá gọi là dái mài (thiên hoài). Lá đơn mọc so le hay mọc đối, hình tim dài, đầu nhọn, nhẵn, dài 8 10 cm, rộng 6 8 cm, gân lá 5 7, tỏa ra từ gốc; cuống lá dài 1,5 3,5 cm. Cụm hoa mọc thành chùm ở kẽ lá gồm nhiều hoa nhỏ, màu vàng, hoa đực và hoa cái khác gốc; bao hoa có 6 phiến dài bằng nhau; nhị 6; cụm hoa đực dài 40 cm, cụm hoa cái cong, dài 20 cm. Quả nang có 3 cánh; khi quả khô, cây không còn lá; hạt có cánh mỏng màu nâu xỉn. Mùa hoa: tháng 5 - 7; mùa quả: tháng 8 - 10 [3]. Hình 1.1. Ảnh vẽ cây Hoài sơn D. hamiltonii Hook.f. [4]
1.3. PHÂN BỐ VÀ SINH THÁI
Phân bố rộng rãi ở các nước châu Á có khí hậu nhiệt đới như vùng đông bắc Ấn Độ (Himalaya, Western Ghats, Assam, Orissa và Bengal), bán đảo Thái Lan, Việt Nam, Lào, Campuchia và Đài Loan [1,5].
Cây thường được tìm thấy mọc hoang ở các rừng hỗn giao, rừng cây bụi, sườn núi, thung lũng và ven đường với độ cao từ 100 m đến 2000 m. Cây phát triển mạnh trong điề
DẠYKÈMQUYNHƠN OFFICIAL 4
u kiện khí hậu nóng ẩm hoặc ôn hòa, với nhiệt độ trungbình khoảng 20 300C và lượng mưa hàng nămtrên 2000 mm. Đồngthời, cây cũng phát triển tốt ở các vùng núi trung du và đồng bằng [1]. Ở Việt Nam, cây Hoài sơn mọc hoang ở khắp các vùng rừng núi. Nhiều nhất tại các tỉnh Hà Bắc, Lào Cai, Yên Bái, Thanh Hóa, Nghệ An, Hà Tĩnh và Quảng Bình [6]. 1.4. THÀNH PHẦN HÓA HỌC 1.4.1. Allantoin Bột hoặc tinh thể màu trắng hay không màu, không mùi, không vị, nóng chảy ở 238,00C. Tan trong nước, ethanol, natri hydroxyd, không tan trong ete ethylic, methanol,… Là một chất lợi tiểu của acid glyoxylic được tạo ra từ acid uric, allantoin đóng vai trò là một chất trung gian trao đổi chính ở hầu hết các sinh vật. Allantoin được sử dụng trong danh mục các chất không kê đơn của Cục quản lý Thực phẩm và Dược phẩm Hoa kỳ như một chất chữa lành vết thương, chất bảo vệ da, sản phẩm trị viêm da tiết dã nhờn, bệnh vảy nến,… [7]. Năm 2014, Trần Thị Oanh và Nguyễn Thị Vân Anh đã định lượng được allantoin có trong 15 mẫu Hoài sơn trồng tại các vùng trồng dược liệu khác nhau ở Việt Nam bằng phương pháp HPLC [8]. Nguyễn Thị Hiền và cộng sự (2015) cũng đã phân lập thành công hợp chất allantoin từ cao chiết methanol của củ Hoài sơn thu hái tại Mê Linh, Vĩnh Phúc, Việt Nam [9].
Hình 1.2. CTCT của allantoin phân
ậ
1.4.2. Acid amin Zhi Cang Wu và cộng sự (2016) đã nghiên c
t của 16 acid amin thiết yếu, không thiết yếu của Hoài sơn (D. hamiltonii) bao gồm threonin, valin, methionin, isoleucin, leucin, phenylalanin, lysin, asparagin, serin, glutamin, glycin, prolin, alanin, tyrosin, arginin và histidin bằng cách sử dụng máy phân tích acid amin tự động (Model L 8900; Hitachi, Tokyo, Nhật Bả
có m
DẠYKÈMQUYNHƠN OFFICIAL 5 NH N H O N H NH2 O O
l
p được từ Hoài sơn [8, 9]
ứu được sự
ặ
n). Phương pháp dựa trên cơ sở dẫn xuất sau cột ninhydrin và phát hiện bằng detector UV (570 nm). Các acid amin sẽ được xác định bằng cách so sánh với thời gian lưu của chất đối chiếu sử dụng norvalin làm chuẩn nội [10]. Bảng 1.1. CTCT của một số acid amin phân tích được trong củ Hoài sơn [10] STT Tên hợp chất CTCT 1 Threonin HO OH O N HH 2 Valin HO O N HH
DẠYKÈMQUYNHƠN OFFICIAL 6 STT Tên hợp chất CTCT 3 Methionin OH N HH O S 4 Isoleucin HO O N HH 5 Leucin OH N HH O 6 Asparagin H N H O N H H OH O 7 Glycin HO N O H H 8 Alanin OH N H H O Năm2015, Nguyễn Thị Hiền và cộng sự cũng đã phân lập được hợp chất cyclo-(phenylalanin-tyrosin) từ cao chiết methanol của củ Hoài sơn thu hái tại Mê Linh, Vĩnh Phúc, Việt Nam. Trong đó, hợp chất này lần đầu tiên được phân lập từ Hoài sơn. Cấu trúc hóa học được xác định dựa trên số liệu của phổ khối lượng và phổ cộng hưởng từ hạt nhân [9].
Hình 1.3. CTCT của cyclo-(phenylalanin-tyrosin) phân lập được từ Hoài sơn [9]
1.4.3. Polyphenol
Cheng cheng Zhao và cộng sự (2019) đã phát hiện được 10 hợp chất polyphenol chứa trong dịch chiết methanol của Hoài sơn (D. hamiltonii) bao gồm acid gallic, acid protocatechuic, acid cholorogenic, acid vanillic, acid syringic, acid p - coumaric, catechin, rutin, quercetol, kaemprefol bằng phương pháp HPLC [11].
Nguyen Thi Thanh Ngan và cộng sự (2020) cũng sử dụng đồng thời 2 phương pháp sắc ký cột và HPLC để phân lập được 8 hợp chất polyphenol (2,4,6,7 tetrahydroxy 9,10 dihydrophenanthren, aerosin, gastrodin, 2 phenyletyl β D glucopyranosid, afzelechin, catechin, acid eucomic và acid vanillic 4 O β D glucopyranosid) từ rễ cây Hoài sơn Cấu trúc hóa học của chúng được xác định bằng phương pháp phân tích khối phổ và cộng hưởng từ hạt nhân [12].
DẠYKÈMQUYNHƠN OFFICIAL 7 OH HN NH O O
DẠYKÈMQUYNHƠN OFFICIAL 8 O OH HO OH OH OH O OH HO OH OH O OH catechin quercetol O OH HO OH OH O OH OH OH HO kaemprefol 2,4,6,7 tetrahydroxy 9,10 dihydrophenanthren OH O O OO OH HO OH OH HOO OH OH OH acid vanillic 4 O β D glucopyranosid afzelechin Hình 1.4. CTCT của một số hợp chất polyphenol phân lập được từ cây Hoài sơn [11,12]
DẠYKÈMQUYNHƠN OFFICIAL 9 1.4.4. Phenanthren Năm 2020, Nguyen Thi Thanh Ngan và cộng sự đã phát hiện được 3 hợp chất phenanthren mới trong thân rễ Hoài sơn (D. hamiltonii) dưới dạng bột vô định hình và đặt tên lần lượt là diospersimilosid A, diospersimilosid B và diosbiphenanthren [12] HO HO O HO OH OH OOH OOH O HOHO OH HO HO OH diospersimilosid A diospersimilosid B OH HO HO OH OH OH HO HO diosbiphenanthren Hình 1.5. CTCT của một số hợp chất phenanthren phân lập được từ thân rễ Hoài sơn [12] 1.4.5. Saponin Một số báo cáo đã cho thấy sự có mặt của 4 hợp chất saponin bao gồm protogracillin, dioscin, diosgenin và trillinđược phânlập từdịchchiết methanol của Hoài sơn bằng phương pháp HPLC [11]. Năm 2020, Raina và cộng sự đã tiến hành sử dụng phương pháp HPLC để phân lập và định lượng thành công diosgenin có trong Hoài sơn thu hái tại Odisha (Ấn Độ) [13].
DẠYKÈMQUYNHƠN OFFICIAL 10 O O O OO HO OH HO O O OH HO O O OH HO OH OH H HH H H HO OH HO OH HO O O O O O O HO HO HO HO HO OH OH O O H HH H H protogracillin dioscin O O H H H OH H H O HO HO OH O O O H H H H H HO diosgenin trillin Hình 1.6. CTCT của một số hợp chất saponin phân lập được từ Hoài sơn [10,12] 1.4.6. Các hợp chất khác Ngoài các saponin và acid amin, Nguyen Van Dan (1990) còn xác định được các thành phần khác có trong thân rễ của cây Hoài sơn (D. hamiltonii) như sau: hydrocarbon 63,25%, protein 6,75%, lipid 0,45%, chất nhầy 2,0 2,8% [14].
Một số báo cáo cũng cho thấy trong loài Hoài sơn có chứa các thành phần bao gồm mucin, cholin và men maltase. Bên cạnh đó còn có d abscicin và dopamin [3].
Năm 2015, Nguyễn Thị Hiền và cộng sự đã tiến hành nghiên cứu phân lập từ cao chiết methanol của củ Hoài sơn thu hái tại Mê Linh, Vĩnh Phúc cho ra hợp chất 1 monolinolenin lần đầu tiên phát hiện trong chi Dioscorea [9]. O OH H
H H H O
Hình 1.7. CTCT của 1 monolinolenin phân
OH H
m nhằm xác định hoạt tính kháng khuẩn đối với d
ch chiết methanol c
m
t s
loại c
dụng hai chất đối chiếu bao gồm streptomycin và dimethyl sulfoxid. Bên cạnh đó, 4 loại vi khuẩn (Streptococus pneumoniae, Shigella dysenteriae
DẠYKÈMQUYNHƠN OFFICIAL 11 thuộc chi Dioscorea ở Tripura (Ấn Độ), trong đó có Hoài sơn bằng phương pháp khuếch tán qua giếng thạch. Nghiên cứu s
lập được từ củ Hoài sơn [9] 1.4. TÁC DỤNG SINH HỌC 1.4.1. Tác dụng kháng khuẩn và kháng nấm Chiranjit Paul và cộng sự (2020) đã tiến hành thử nghiệ
ị
ủa
ộ
ố
ủ
ử
, Klebsiella pneumonia, Escherichia coli) và 2 loại nấm (Candida tropicalis, Candida albicans) gây bệnhcũngđược sửdụng. Khả năngkhángkhuẩnđược xác địnhbằngkíchthước vùng ức chế (tính bằng milimét) xung quanh các khuẩn lạc vi sinh vật tương ứng. Kết quả ghi nhận, dịch chiết methanol của D. hamiltonii đã thể hiện được đặc tính kháng khuẩn và kháng nấm, trong đó đáng chú ý là khả năng chống lại phế cầu khuẩn Streptococus pneumonia [15].
DẠYKÈMQUYNHƠN OFFICIAL 12 Hình 1.8. Hoạt động kháng khuẩn của củ đực và củ cái của một số loài thuộc chi Dioscorea [15] a, b: hoạt động kháng khuẩn của một số loài thuộc chi Dioscorea đối với Streptococus pneumonia và Shigella dysenteriae. c, d: hoạt động kháng nấm của một số loài thuộc chi Dioscorea đối với Candida tropicalis và Candida albicans Bảng 1.2. Hoạt động kháng khuẩn của dịch chiết củ đực và củ cái loài D. hamiltonii được thu hái ở Tripura (Ấn Độ) [15] Phân loại Vùng ức chế (tính bằng milimét) Chủng vi khuẩn Chủng nấm A B C D E F Củ đực 11,80 ± 1,05 6,93 ± 0,15 7,23 ± 0,32 Củ cái 12,13 ± 0,75 8,70 ± 0,36 ( ): không xác định A: Klebsiella pneumonia, B: Streptococus pneumonia, C: Escherichia coli, D: Shigella dysenteriae, E: Candida albicans, F: Candida tropicalis
Năm 2010, Kaladhar và cộng sự đã đánh giá tác dụng kháng khuẩn của dịch chiết Hoài sơn trên các vi khuẩn gram (+) (Enterococcus faecalis, Streptococcus pyogenes, Bacillus subtilis, Streptococcus thermophiles, Lacto bacillus delbrueckii), gram ( ) (Escherichia coli, Vibrio parahaemolyticus, Pseudomonas aeruginosa, Proteus vulgaris) và nấm (Aspergillus niger, Penicillium chrysogenum, Saccharomyces cerevisiae). Để thực hiện thử nghiệm, người ta sử dụng môi trường nuôi cấy bao gồmdung dịch thạch Muller Hilton (MHA) đối với sự phát triể
đĩa để làm đông đặc. Bằng cách sử dụng phương pháp đục lỗ thạch, các giếng có đường kính 8 mm đã được tạo ra trên đĩa để bổ sung các dịch chiết D. hamiltonii có nồng độ 25 mg/ml. Các chất chuẩn được sử dụng gồm ampicillin 10 mg/ml, penicillin 10 mg/ml và griseofulvin 10 mg/ml. Mức độ kháng khuẩn được xác định bằng đường kính vùng ức chế xung quanh giếng (tính bằng milimét) sau khi đã ủ dịch chiết được 24 48 giờ đối với vi khuẩn, nấm men và 2 ngày
DẠYKÈMQUYNHƠN OFFICIAL 13
n của vi khuẩn và thạch Sabourad Dextrose (SDA) đối với sự phát triển của nấm. Các môi trường này được hấp tiệt trùng trong vòng 20 phút ở 1210C và làm lạnh đến 450C. Sau đó, các mẫu vi khuẩn và nấm được cấy lần lượt vào trong 500 ml MHA và SDA. 20 ml môi trường đã nuôi cấy này được đổ lên các
đối với nấm. Kết quả cho thấy, các dịchchiết đềuthể hiệnđược hoạt tínhkhángkhuẩn tốt, đặc biệt là dịchchiết methanol của D. hamiltonii (đường kính vùng ức chế 11 24 mm) [16] Bảng 1.3. Hoạt tính kháng khuẩn của dịch chiết D. hamiltonii [16] Vùng ức chế (bao gồm kích thước giếng thạch 8 mm) Vi sinh vật A B C D Chất chuẩn Escherichia coli 19 15 17 13 17 Ampicillin Vibrio parahaemolyticus 18 15 19 13 18 Ampicillin Enterococcus faecalis 19 17 18 12 20 Ampicillin
aeruginosa 15 15 17 13 17 Ampicillin
Proteus vulgaris 18 17 16 14 20 Ampicillin
Streptococcus pyogenes 24 21 20 17 24 Penicillin
Bacillus subtilis 23 19 22 14 25 Penicillin
Streptococcus thermophiles 21 20 20 16 23 Penicillin
Lactobacillus delbrueckii 24 22 22 13 14 Penicillin
Aspergillus niger 11 10 10 9 14 Griseofulvin Penicillium chrysogenum 11 10 10 9 13 Griseofulvin
Saccharomyces cerevisiae 20 19 20 17 19 Griseofulvin
DẠYKÈMQUYNHƠN OFFICIAL 14 Vùng ức chế (bao gồm kích thước giếng thạch 8mm) Vi sinh vật A B C D Chất chuẩn Pseudomonas
A: dịch chiết methanol (25 mg/ml), B: dịch chiết ethanol (25 mg/ml), C: dịch chiết ethyl acetat (25 mg/ml), D: dịch chiết nước (25 mg/ml). Ampicillin 10 mg/ml, penicillin 10 mg/ml và griseofulvin 10 mg/ml. 1.4.2. Tác dụng chống oxy hóa Bandana Padhan và cộng sự (2020) đã thực hiện các thử nghiệm nhằm đánh giá hoạt động chống oxy hóa trên chiết xuất methanol của một số loài thuộc chi Dioscorea thu hái tại Koraput (Ấn Độ), trong đó có Hoài sơn. Hoạt tính chống oxy hóa được xác định dựa trên khả năng thu gom các gốc tự do khác nhau bao gồm DPPH, ABTS, nitric oxid và anion superoxid. Các thí nghiệm nàyđược tiến hành lần lượt theo phươngpháp của Blois (1958),
Re và cộng sự (1999), Green và cộng sự (1982), Robak và Gryglewski (1988) với các chất đối chiếu được sử dụng gồm acid ascorbic, trolox và quercetin. Các phép đo ở mỗi thử nghiệm đều được tiến hành 3 lần độc lập và tính toán giá trị trung bình. Hoạt động chống oxy hóa được biểu thị dưới dạng IC50 (µg*ml 1) Kết quả cho thấy, tuy khả năng chống oxy hóa vẫn yếu hơn
DẠYKÈMQUYNHƠN OFFICIAL 15
đáng kể so với các chất chuẩn sử dụng nhưng dịch chiết methanol của D. hamiltonii vẫn thể hiện được hoạt tính này thông qua việc thu dọn các gốc tự do, đặc biệt là khả năng thu gom gốc ABTS. Hoạt tính này được cho là do tính chất của các thành phần flavonoid và polyphenol gây nên [17]. Hình 1.9. Biểu đồ thể hiện giá trị IC50 về khả năng thu dọn gốc tự do của dịch chiết methanol loài D. hamiltonii với mẫu đối chứng (acid ascorbic, trolox và quercetin) [17] Aušra Adomėnienė và Petras Rimantas Venskutonis (2022) cũng tiến hành đánh giá đặc tính chống oxy hóa của D. hamiltonii dựa trên khả năng khửsắt theo phươngpháp FRAP. Nguyêntắc của phương pháp này là làm giảm 0 100 200 300 400 500 600 700 800 DPPH ABTS Superoxid Nitric oxid D. hamiltonii Acid ascorbic Trolox Quercetin IC 50 (µg ml 1 )
các phức hợp ferric - tripyridyltriazin. Dịch chiết methanol của Hoài sơn ở các nồng độ khác nhau sẽ được cho phản ứng với dung dịch FRAP và sau đó xác định mật độ quang ở những điều kiện và bước sóng thích hợp. Trong thử nghiệm này, acid ascorbic được sử dụng làm chất chuẩn. Kết quả cho thấy, hàm lượng chất oxy hóa tương đương chất chuẩn của dịch
chống oxy hóa của D. hamiltonii bằng thử nghiệm in - vivo trên động vật. Để tiến hành đánh giá, người ta sử dụng dịch chiết methanol của D. hamiltonii với liều uống 2 g/kg và 6 g/kg cân nặng cho chuột cống và chuột nhắt thí nghiệm bị phù tai do xylen. Sau 5 ngày, dịch chiết đã làm giảm mức độ của các cytokin gây viêm và đồng thời làm giảm stress oxy hóa [18].
1.4.3. Tác dụng hạ đường huyết
Bao zou He và cộng sự (2014) đã tiến hành đánh giá tác dụng hạ đường huyết của Hoài sơn (D. hamiltonii) trên động vật thí nghiệm Trong giai đoạn
1 của nghiên cứu này, bột rễ củ Hoài sơn sẽ được chiết xuất với dung môi ethanol bằng phương pháp ngâm. Sau đó, lấy dịch chiết và thực hiện một số thao tác với tinh bột và các dung môi gồm chloroform, ethyl acetat, ethanol, thu được phần dịch hơi lỏng, màu nâu đem tiến hành đánh giá (1). Ở giai đoạn 2, chuột lai Côn Minh (trọng lượng 22 32 g) sẽ được tiêm tĩnh mạch alloxan liều 70 mg/kg và tiế
DẠYKÈMQUYNHƠN OFFICIAL 16
chiết D. hamiltonii (mg acid ascorbic/g dịch chiết) đã được tính toán và xác định giá trị bằng 3,30. Tuy hàm lượng này tương đối thấp nhưng đã phần nào thể hiện được hiệu quả chống oxy hóa của D. hamiltonii khi tiến hành theo phương pháp trên [18,19]. Bên cạnh đó, Aušra Adomėnienė và Petras Rimantas Venskutonis cũng đánh giá đặc tính
n hành lấy máu tĩnh mạch (nhịn ăn 12 giờ trước khi lấy máu) sau khi cho ăn bình thường trong vòng 72 giờ. Chia số động vật được chọn (lượng đường huyết ≥ 10 mmol/l) thành 5 nhóm ngẫu nhiên với phân tích phương sai cho thấy không có sự khác biệt đáng kể về giá trị đường huyết. Sau đó, thành lập 2 nhóm chứng và cho sử dụng cùng một lượng nước muối thông thường. 3 nhóm thử còn lại lần lượt được uống các liều thấp (200 mg dịch chiết (1)/kg), trung bình (800 mg dịch chiết (1)/kg) và cao (3 g dịch chiết (1)/kg). Các liều được sử dụng liên tục mỗi ngày 1 lần trong vòng 7 ngày và tiến hành lấy máu tĩnh mạch chuột sau 2 h uống thuốc cuối cùng. Đo lượng đường và
DẠYKÈMQUYNHƠN OFFICIAL 17 đếm số lượng chuột có nồng độ đường máu hợp lệ (nồng độ đường máu 6,72 - 7,38 mmol/l hoặc nồng độ đường máu giảm 30% so với ban đầu) và không hợp lệ. Kết quả cho thấy, phần dịch chiết (1) có tác dụng làm hạ đường huyết trên chuột thí nghiệm [20]. Bảng 1.4. Kết quả đo lượng đường máu trong chuột thử nghiệm 1 [20] Nhóm Số lượng chuột hợp lệ Số lượng chuột không hợp lệ Tổng Hiệu quả (%) Nhóm chứng 1 2 8 10 20,00 Nhóm liều thấp (200 mg dịch chiết (1)/kg) 1 7 8 12,50 Nhóm liều trung bình (800 mg dịch chiết (1)/kg) 0 7 7 0,00 Bảng 1.5. Kết quả đo lượng đường máu trong chuột thử nghiệm 1 [20] Nhóm Số lượng chuột hợp lệ Số lượng chuột không hợp lệ Tổng Hiệu quả (%) Nhóm chứng 2 0 10 10 0,00 Nhóm liều cao (3 g dịch chiết (1)/kg) 6 5 11 54,55* * p < 0,05 so với nhóm chứng 2
ng tại các thời điểm này là 13,2 và 12,2 mmol/l (p < 0,05) Đây là một kết quả có giá trị cho nghiên cứu tính đề kháng của tinh bột Hoài sơn dưới tác động của hệ men trong cơ thể người đối với việc hạn chế gia tăng lượng đường huyết [21]. 1.4.4. Một số tác dụng sinh học khác Tác dụng đồng hóa và hướng sinh dục: Uống bột thân rễ Hoài sơn trong vòng 28 ngày liên tiếp làm tăng trọng lượng tử cung của chuột bạch tạng cái. Đồng thời cũng làm tăng trọng lượng của các túi, tuyến tiền liệt, túi tinh và cơ nâng hậu môn của chuột bạch tạng đực [1]. Cải thiện hội chứng suy nhược lá lách ở chuột: Các nghiên cứu in vivo đã chứng minh việc sử dụng Hoài sơn có thể cải thiện hội chứng suy nhược lá lách ở chuột.
DẠYKÈMQUYNHƠN OFFICIAL 18 Trần Hữu Dũng (Trường Đại học Y Dược Huế) cũng tiến hành khảo sát những ảnh hưởng của tinh bột Hoài sơn (D. hamiltonii) đối với nồng độ đường máu trên người tình nguyện bị đái tháo đường typ 2 tại Huế và Quảng Bình. Phươngpháp chéo mùđôi2 giaiđoạnđược lựa chọnthực hiện. Các tìnhnguyện viên sau khi được kiểm tra đường huyết (nhịn ăn 12 14 giờ trước thời điểm lấy máu) sẽ được phát 1 trong 2 khẩu phần ăn gồm 2 bánh giống nhau (mẫu chứng 2 bánh bột mì hoặc mẫu thử 2 bánh bột Hoài sơn). Kết quả nghiên cứu sẽ được lấy giá trị trung bình từ 60 mẫu khác nhau. Từ kết quả đánh giá cho thấy, nồng độ đường máu trước thời điểm ăn 2 mẫu bánh khác nhau không có sự khác biệt đáng kể (p > 0,05). Tuy nhiên, tại thời điểm sau ăn 60 phút và 120 phút, nồng độ đường máu của mẫu thử lần lượt là 10,3 và 9,5 mmol/l, thấp hơn nhiều so với nồng độ đường máu của mẫu chứ
Trong đó, trọng lượng, nhiệt độ cơ thể, trọng lượng tuyến ức, lá lách cùng mức xylose trong huyết thanh đã tăng lên đáng kể bởi Hoài sơn [1]. Tác dụng độc tế bào: Nguyen Thi Thanh Ngan và cộng sự (2020) đã tiến hành đánh giá tác dụng gây độc tế bào đối với 3 dòng tế bào ung thư người bao gồm HepG2, MCF-7 và SK-Mel-2 của các hợp chất phân lập được từ củ Hoài sơn (D. hamiltonii) thu hái tại Vĩnh Phúc. Phương pháp SRB (Sulforhodamin B) được lựa chọn để tiến hành nghiên cứu. Kết quả cho thấy, các hợp chất chuyển hóa phenalthren (diosbiphenanthren, 2,4,6,7 tetrahydroxy 9,10
DẠYKÈMQUYNHƠN OFFICIAL 19 dihydrophenanthren, aerosin) là chất độc đối với tất cả các dòng tế bào ung thư với IC50 trong khoảng 8,2 - 68,4 µM. Các hợp chất còn lại không hoạt động ở nồng độ khảo sát (IC50 > 100 µM) [12]. Bảng 1.6. Tác dụng gây độc tế bào của củ Hoài sơn thu hái tại Vĩnh Phúc [12] Hợp chất IC50 (µM)a HepG2 MCF 7 SK Mel 2 Diosbiphenanthren 16,9 ± 1,4 8,2 ± 0,5 15,6 ± 1,4 2,4,6,7-tetrahydroxy-9,10dihydrophenanthren 22,8 ± 2,2 11,2 ± 1,3 14,4 ± 1,3 Aerosin 68,4 ± 8,2 42,2 ± 1,1 64,2 ± 7,0 Ellipticinb 1,58 ± 0,04 1,62 ± 0,03 2,15 ± 0,04 a: kết quả được thể hiện dưới dạng giá trị ± SD (n = 3). b: chứng dương. 1.5. TÁC DỤNG VÀ CÔNG DỤNG THEO Y HỌC CỔ TRUYỀN Theo Y học cổ truyền, Hoài sơn có vị ngọt, tính bình, quy vào 4 kinh phế, tỳ, vị, thận. Có tác dụng bổ tỳ, dưỡng vị, sinh tân, ích phế, bổ thận và chỉ khái. Thân rễ có tác dụng phục hồi và chống nhiễm trùng. Dùng chữa tỳ vị hư nhược, ăn uống kém tiêu, viêm ruột mạn tính, tiêu chảy lâu ngày không khỏi, phế hư ho hen, bệnh tiểu đường, di tinh, di niệu, bạch đới và mụn nhọt ngoài da [1,3]. Hoài sơn phối hợp với quả gian, hạt keo, ý dĩ có tác dụng chữa trẻ em cam sài, gầy yếu, bụng ỏng đít beo, kém ăn nôn trớ [3]. Ở Bangladesh, bột lá Hoài sơn được người dân tộc Chakma sử dụng để điều trị bệnh vàng da và quai bị [1].
M
1. Hoài sơn 10
Đẳ
B
Ch
2. Hoài
Ngũ
Nh
Đỗ
Th
Ch
180
120
90
30
Ba
Th
Ngưu
Tr
Xích
30
30
30
tay
mình
DẠYKÈMQUYNHƠN OFFICIAL 20
ột số bài thuốc chứa Hoài sơn:
g
ng sâm 10 g
ạch truật 10 g
ủ trị: tỳ vị hư nhược, ăn ít, đái nhiều, tiêu chảy lâu không khỏi.
sơn 60 g
kích
g
vị tử
g
ục địa 30 g
ục thung dung
g
tất 30 g
trọng
g
ạch tả
g
ần phục
g
thạch chỉ
g
ủ trị: đau đầu, chóng mặt, chân
lạnh, đau
mẩy, ăn uống kém. 3. Hoài sơn 180 g Ngũ vị tử 350 g Liên tử 90 g Thỏ ty tử 300 g Phục linh 40 g Chủ trị: tiểu đường. 4 Hoài sơn 10 phần Cẩu tích 8 phần Ba kích 12 phần Độc hoạt 8 phần đỗ trọng 12 phần Ngũ gia bì 10 phần Ngưu tất 12 phần Sơn thù du 10 phần Quế tâm 8 phần Phòng phong 6 phần Chủ trị: dương ủy, lưng đau [3]. 5 Hoài sơn giã nhỏ Chủ trị: mụn nhọt [6]
DẠYKÈMQUYNHƠN OFFICIAL 21 CHƯƠNG 2 - NGUYÊN VẬT LIỆU VÀ PHƯƠNG PHÁP NGHIÊN CỨU 2.1. NGUYÊN VẬT LIỆU NGHIÊN CỨU 2.1.1. Nguyên liệu Rễ củHoàisơnđược thu hái vào tháng03 năm2022 tạihuyệnNho Quan, tỉnh Ninh Bình. Mẫu thực vật được Viện Sinh thái và Tài nguyên sinh vật giám định tên khoa học là Dioscorea hamiltonii Hook.f., họ Củ nâu: Dioscoreaceae (PHỤ LỤC 1). Mẫu dược liệu khô: Rễ củ của cây Hoài sơn được rửa sạch, thái lát, sấy khô, nghiền nhỏ, bảo quản để sử dụng nghiên cứu. 2.1.2. Dung môi, hóa chất, thuốc thử Bảng 2.1. Các dung môi, hóa chất, thuốc thử dùng trong nghiên cứu Phân loại Tên dung môi, thuốc thử Nguồn gốc Tiêu chuẩn Dung môi Acetonitril Đức Tiêu chuẩn tinh khiết phân tích Chloroform Đức Tiêu chuẩn tinh khiết phân tích Ethanol 96% Việt Nam DĐVN V Nước cất Học viện Quân Y Tiêu chuẩn cơ sở Chất chuẩn Allantoin 20mg (98,5%) Trung Quốc Chuẩn đối chiếu Dược liệu chuẩn Hoài sơn (bột) Việt Nam Chuẩn đối chiếu Hóa chất Vanillin Trung Quốc Tiêu chuẩn cơ sở Acid phosphoric Trung Quốc Tiêu chuẩn tinh khiết phân tích
DẠYKÈMQUYNHƠN OFFICIAL 22 Chất phát hiện màu dùng trong sắc kí lớp mỏng: dung dịch vanillin 1% trong hỗn hợp acid phosphoric - methanol (1:1). Các hóa chất khác cần thiết dùng trong phòng thí nghiệm. 2.1.3. Trang thiết bị và dụng cụ nghiên cứu Bảng 2.2. Các thiết bị, dụng cụ nghiên cứu Tên thiết bị, dụng cụ Xuất xứ Cân phân tích điện tử Mettler Todedo - MS 205DU độ chính xác 0,1 mg Thụy Sỹ Cân kỹ thuật Mettler Todedo MS 205DU độ chính xác 0,01 g Thụy Sỹ Máy xay HuangCheng Trung Quốc Tủ sấy Memmert UNB400 Đức Bản mỏng Silica gel GF254 (Merck) Đức Kính hiển vi Zeiss Primo star Đức Đèn tử ngoại Vilber Loumart Pháp Máy ly tâm Sigma Đức Máy siêu âm Elmasonic Mỹ Máy đo hàm ẩm tự động ADAM AMB 310 Đức Dụng cụ chiết hồi lưu Trung Quốc Hệ thống HPLC Hitachi DAD ELSD (Phần mềm xử lý số liệu Open LAB Control Panel) Nhật Bản Cột sắc ký Zorbax CN SB Mỹ Giấy lọc, bình cầu, đũa thủy tinh, cốc thủy tinh các loại Trung Quốc
2.2. PHƯƠNG PHÁP NGHIÊN CỨU
2.2.1. Phương pháp mô tả
- Tiến hành quan sát đặc điểm bên ngoài, đo kích thước, nếm vị và ngửi mùi của rễ củ đã làm khô. Mô tả các đặc điểm quan sát được.
2.2.2. Phương pháp soi bột
- Tiến hành làm tiêu bản bột rễ củ Hoài sơn và soi dưới kính hiển vi quang học, tìm các đặc điểm của bột rễ củ
DẠYKÈMQUYNHƠN OFFICIAL 23
. Cách tiến hành: theo DĐVN V, phụ lục 12.18. + Nghiền mịn dược liệu. + Lấy 0,05 g bột (đã rây qua rây số 250) cho vào một giọt nước đã có sẵn trên lam kính, dùng kim mũi mác dàn đều cho bột thấm dung dịch, đậy và di nhẹ lam kính. + Quan sát dưới kính hiển vi ở các vật kính 10x, 40x. Chụp hình kết quả ở vật kính 40x. 2.2.3. Phương pháp định tính Tiến hành theo DĐVN V, Chuyên luận Củ mài 2.2.3.1. Hiện tượng huỳnh quang Dựa trên khả năng hấp thụ ánh sáng ở bước sóng khác nhau của các hợp chất [21]. - Quan sát bột dược liệu dưới ánh sáng tử ngoại bước sóng 366 nm. 2.2.3.2. Sắc ký lớp mỏng Dựa trên kỹ thuật tách các chất cần phân tích khi cho pha động di chuyển pha tĩnh (một lớp chất hấp thụ trơ) trên đó đã chấm hỗn hợp các chất cần tách [22]. Điều kiện sắc ký: + Bản mỏng: silicagel 60GF254.
+ Dung môi triển khai: chloroform - methanol (9:1).
+ Lượng chấm: 15 µl.
+ Dung dịch hiện vết: dung dịch vanillin (TT) 1% trong hỗn hợp acid phosphoric methanol (1:1).
Chuẩn bị mẫu:
+ Dung dịch thử: lấy 0,5 g bột dược liệu, thêm 5 ml hỗn hợp chloroform methanol (4:1), đun sôi dưới ống sinh hàn hồi lưu khoảng 10 phút. Để nguội, lọc, cô dịch lọc đến cắn, hòa cắn trong 1 ml ethanol (TT) làm dung dịch chấm sắ
bản mỏngthànhcác bảnnhỏ kíchthước khoảng 2 cm x 7 cm và hoạt hoá trong tủ sấy ở 105 1100C trong 30 phút. Ðể nguội rồi bảo quản trong bình hút ẩm. Kẻ một đường chì ở mặt silica cách đáy khoảng 0,5 1 cm.
Cách tiến hành: dùng mao quản chấm riêng biệt lên bản mỏng 15 µl mỗi dung dịch trên. Sau khi triển
DẠYKÈMQUYNHƠN OFFICIAL 24
c ký. + Dung dịch đối chiếu: lấy 0,5 g bột Hoài sơn (mẫu chuẩn), tiến hành chiết như mô tả ở phần Dung dịch thử. Chuẩnbịbản mỏng:cắt
khai sắc ký, phun dung dịch vanillin (TT) 1% trong hỗn hợp acid phosphoric methanol (1:1). Sấy bản mỏng ở 1200C đến khi hiện rõ vết. Quan sát dưới ánh sáng tử ngoại bước sóng 366 nm. Yêu cầu: trên sắc ký đồ của dung dịch thử phải có các vết có cùng màu và giá trị Rf với các vết trên sắc ký đồ của dung dịch đối chiếu. 2.2.4. Phương pháp xác định độ ẩm Tiến hành theo phương pháp mất khối lượng do làm khô của DĐVN V, phụ lục 9.6. Cách tiến hành: cân khoảng 1,0 g bột rễ củ, sấy ở 850C trong thời gian 5 giờ. Theo dõi và ghi kết quả. Yêu cầu: không quá 14,0%.
Phương pháp xác
nh
toàn
hành theo phương pháp
phương
không cháy trong
tách các
tích
cháy
toàn
chén
cân
Nung
không quá 450
C
chén
u, lọc qua giấy lọc không tro. Rửa đũa thủy tinh và giấy lọc, tập trung nước rửa vào dịch lọc. Cho giấy lọc và cắn vào chén nung rồi nung đến khi thu được tro màu trắng hoặc gần như trắng. Tập trung dịch lọc vào cắn trong chén nung, đem bốc hơi đến khô rồi nung ở nhiệt độ không quá 4500C đế
DẠYKÈMQUYNHƠN OFFICIAL 25 2.2.5.
đị
tro
phần Tiến
xác định tro
phần của DĐVN V, phụ lục 9.8,
pháp 1. Dựa trên khả năng
chất dễ
ra khỏi các chất hữu cơ
mẫu phân
ở nhiệt độ cao [24]. Cách tiến hành: + Cho 2 3 g bột dược liệu vào một
sứ hoặc
platin đã nung và
bì.
ở nhiệt độ
0
tới khi không còn carbon, làm nguội rồi cân. + Nếu tro chưa loại hết carbon, dùng một ít nước nóng cho vào khối chất đã than hóa, dùng đũa thủy tinh khuấy đề
n khi khối lượng không đổi. + Tính tỷ lệ phần trăm cùa tro toàn phần theo dược liệu đã làm khô trong không khí. Yêu cầu: không quá 4,0%. 2.2.6. Phương pháp xác định tạp chất 2.2.6.1. Dược liệu có màu vàng và đỏ Kiểm tra bằng cảm quan. Yêu cầu: không được có. 2.2.6.2. Tạp chất Tiến hành theo phương pháp xác định tạp chất lẫn trong dược liệu của DĐVN V, phụ lục 12.11. Cách tiến hành: Cân 50 g rễ củ Hoài sơn thái lát, dàn mỏng trên tờ giấy, quan sát bằng mắt thường hoặc kính lúp, khi cần có thể dùng rây để phân tách tạp chất và dược liệu. Cân phần tạp chất và tính tỷ lệ phần trăm.
- Yêu cầu: không quá 0,5%.
2.2.7. Phương pháp xác định các chất chiết được trong dược liệu
2.2.7.1. Chất chiết được trong nước
- Tiến hành theo phương pháp xác định các chất chiết được bằng nước của DĐVN V, phụ lục 12.10, phương pháp chiết lạnh.
Cách tiến hành:
+ Cân chính xác khoảng 4,000 g bột dược liệu có cỡ bột nửa thô cho vào trong bình
bình
khô thích h
p. L
y chính xác 20 ml d
ch l
c cho vào một cốc thủy tinh đã cân bì trước, cô trong cách thủy đến cắn khô.
+ Sấy cắn ở 1050C trong 3 giờ, lấy ra để nguội trong bình hút ẩm30 phút, cân nhanh để xác định khối lượng cắn sau khi sấy. Tính phần trăm lượng chất chiết được bằng nước theo dược liệu khô.
- Yêu cầu: không ít hơn 5,0% tính theo dược liệu khô kiệt. 2.2.7.2. Chất chiết được trong cồn
- Tiến hành
DẠYKÈMQUYNHƠN OFFICIAL 26
nón 250 ml. Thêm chính xác 100,0 ml nước, đậỵ kín, ngâm lạnh, thỉnh thoảng lắc trong 6 giờ đầu, sau đó để yên 18 giờ. + Lọc qua phễu lọc khô vào một
hứng
ợ
ấ
ị
ọ
theo phương pháp xác định các chất chiết được bằng methanol hoặc ethanol của DĐVN V, phụ lục 12.10. Cách tiến hành: + Cân chính xác khoảng 4,000 g bột dược liệu có cỡ bột nửa thô cho vào trong bình nón 250 ml. Thêm chính xác 100,0 ml ethanol 70% (TT), đậỵ kín, ngâm lạnh, thỉnh thoảng lắc trong 6 giờ đầu, sau đó để yên 18 giờ. + Lọc qua phễu lọc khô vào một bình hứng khô thích hợp. Lấy chính xác 20 ml dịch lọc cho vào một cốc thủy tinh đã cân bì trước, cô trong cách thủy đến cắn khô.
T
Nhi
độ dòng: 0,2 ml/phút.
Pha độ
nước (2:98).
chính xác khoảng 5 mg chất chuẩn allantoin cho vào bình định mức 10 ml, hòa tan trong vừa đủ thể tích bằng nước. Lắc đều để được dung dịch chuẩ
DẠYKÈMQUYNHƠN OFFICIAL 27 + Sấy cắn ở 1050C trong 3 giờ, lấy ra để nguội trong bình hút ẩm30 phút, cân nhanh dể xác định khối lượng cắn sau khi sấy. Tính phần trăm lượng chất chiết được bằng ethanol 70% (TT) theo dược liệu khô. Yêu cầu: không ít hơn 4,0% tính theo dược liệu khô kiệt. 2.2.8. Phương pháp định lượng allantoin bằng sắc ký lỏng hiệu năng cao Dựa vào các tài liệu [8,25] về định lượng allantoin trong củ Hoài sơn bằng phương pháp HPLC, lựa chọn các điều kiện tiến hành sắc ký (có chỉnh sửa để phù hợp với điều kiện của phòng thí nghiệm) như sau: 2.2.8.1. Điều kiện phân tích Cột sắc ký: Cột Zorbax CN SB (150 x 4,6 mm, 5 µm). Detector: UV 215 nm. Thể tích tiêm: 20 µl
ốc
ệt độ phòng cột: 250C
ng: methanol
2.2.8.2. Chuẩn bị mẫu phân tích a. Chuẩn bị dung dịch chuẩn Cân
n gốc có nồng độ khoảng 500 µg/ml. Từ dung dịch chuẩn gốc, tiến hành pha loãng trong các bình định mức thành dãy các dung dịch có nồng độ khác nhau (12,5 25 50 75 100 125 µg/ml). Sau đó, lọc qua màng 0,45 µm và tiến hành phân tích HPLC. b. Chuẩn bị dung dịch thử Cân chính xác khoảng 1,0 g bột dược liệu cho vào bình nón, thêm 2,5 ml nước lắc nhẹ tạo thành hỗn dịch. Thêm 25 ml ethanol 95%, lắc siêu âm trong vòng 30 phút ở nhiệt độ phòng và sau đó bảo quản ở 40C qua đêm. Lọc qua
giấy lọc băng xanh. Tập trung dịch rửa và dịch lọc cô cách thủy đến cắn. Hòa tan cắn trong 5 ml nước cất (siêu âm trong vòng 15 phút). Ly tâm dung dịch thu được ở 40C, tốc độ 7700 vòng/phút trong vòng 15 phút. Lấy chính xác 1 ml dịch trong, cho vào bình định mức 10 ml, thêm nước vừa đủ. Lắc đều, lọc qua màng 0,45 µm và tiến hành phân tích HPLC.
c. Tính toán kết quả
DẠYKÈMQUYNHƠN OFFICIAL 28
Hàm lượng allantoin P (mg/g) trong dược liệu (tính theo dược liệu khô kiệt) được tính theo công thức sau đây: P = C m x (1 - R) x 10 Trong đó, m: khối lượng dược liệu (g). R: độ ẩm dược liệu. C: nồng độ (µg/ml) allantoin trong dung dịch thử (dung dịch tiêm sắc ký). Nồng độ allantoin trong dung dịch thử được tính dựa vào phương trình hồi quy được thiết lập trong khoảng nồng độ allantoin (12,5 125 µg/ml) với hệ số tương quan lớn hơn 0,9995 2.2.8.3. Thẩm định phương pháp định lượng Phương pháp định lượng được tiến hành dựa trên các tài liệu [8,25], do đó không tiến hành thẩm định toàn bộ các chỉ tiêu yêu cầu đối với xây dựng một quy trình mới mà chỉ thẩm định một số tiêu chí nhằm đánh giá giá trị sử dụng của phương pháp, bao gồm tính tương thích hệ thống, độ đặc hiệu chọn lọc, khoảng tuyến tính và độ lặp lại. a. Tính tương thích hệ thống Tiến hành tiêm lặp lại 6 lần cùng một dung dịch chuẩn allantoin vào hệ thống sắc ký theo chương trình đã lựa chọn. Độ thích hợp của hệ thống
b.
(không
(không quá 2%) [26].
c hi
trắng
Dung dịch chuẩn
chuẩn
pha
mục 2.2.8.2
Dung dịch
thử
mục 2.2.8.2. Ti
n hành
kiện đã lựa chọn và ghi sắc ký đồ c
u tr
dung
ch thử để so sánh.
a m
DẠYKÈMQUYNHƠN OFFICIAL 29 HPLC được biểu thị qua độ lệch chuẩn tương đối RSD (%) của thời gian lưu, diện tích pic, hệ số đối xứng và số đĩa lý thuyết. Dung dịch chuẩn: sử dụng dung dịch chuẩn đã pha ở mục 2.2.8.2. Thực hiện tiêm 6 lần dung dịch chuẩn allantoin có nồng độ 12,5 μg/ml và tiến hành sắc ký theo điều kiện đã lựa chọn. Xác định độ lệch chuẩn tương đối (RSD) của 6 phép thử về diện tích pic, thời gian lưu, hệ số đối xứng và số đĩa lý thuyết. Yêu cầu: độ lệch chuẩn tương đối RSD (%) của thời gian lưu (không quá 1%), diện tích pic
quá 2%), hệ số đối xứng (không quá 2%) và số đĩa lý thuyết
Độ đặ
ệu chọn lọc Mẫu
: nước.
: sử dụng dung dịch
đã
ở
.
thử: sử dụng dung dịch
đã pha ở
ế
sắc ký trong điều
ủ
ẫ
ắng,
dịch chuẩn, dung dị
Yêu cầu: thời gian lưu pic chính trên sắc ký đồ dung dịch thử phải tương ứng với thời gian lưu của pic allantoin trên sắc ký đồ dung dịch chuẩn. Trên sắc ký đồ của mẫu trắng không phát hiện pic tại vị trí thời gian lưu của pic allantoin hoặc có phát hiện nhưng hệ số ảnh hưởng không vượt quá 20% [26] c. Khoảng tuyến tính Khảo sát sự phụ thuộc tuyến tính giữa nồng độ với diện tích pic của allantoin trong khoảng 12,5 µg/ml đến 125 µg/ml. Dung dịch chuẩn: sử dụng dung dịch mẫu chuẩn đã pha ở mục 2.2.8.2.
Dung
DẠYKÈMQUYNHƠN OFFICIAL 30 Tiến hành phân tích dãy dung dịch chuẩn theo điều kiện sắc ký đã lựa chọn. Từ các giá trị diện tích pic, xây dựng đường chuẩn sự phụ thuộc của diện tích pic vào nồng độ của dung dịch allantoin. Yêu cầu: hệ số tương quan của đường chuẩn không dưới 0,99 [26]. d. Độ chính xác
dịch thử: dung dịch mẫu thử được chuẩn bị như mục 2.2.8.2. Tiến hành phân tích dung dịch thử lặp lại 6 lần trong cùng 1 ngày với điều kiện sắc ký đã lựa chọn. Xác định RSD (%) của 6 giá trị phép thử thu được. Yêu cầu: RSD không quá 2%. 2.3. XỬ LÝ KẾT QUẢ Các kết quả được xử lý bằng phần mềm MS Excel 2016 Giá trị trung bình: X = ∑ = xi n i=1 n - Độ lệch chuẩn: SD = √∑ (xi X)2n i n 1 Độ lệch chuẩn tương đối: RSD = SD X x 100 2.4. ĐỊA ĐIỂM THỰC HIỆN Bộ môn Dược liệu Dược học cổ truyền, Viện Đào tạo Dược Học viện Quân Y. Khoa Hóa phân tích Tiêu chuẩn, Viện Dược liệu Trung ương. Phòng Đông dược Viện Kiểm nghiệm Thuốc Trung ương.


DẠYKÈMQUYNHƠN OFFICIAL 31 CHƯƠNG 3 - KẾT QUẢ NGHIÊN CỨU VÀ BÀN LUẬN 3.1. KẾT QUẢ MÔ TẢ Sau khi quan sát và đo kích thước, nhận thấy rễ củ khô Hoài sơn có các đặc điểm cơ bản như sau: Rễ củ phình to, có nhiều hình dạng, phổ biến nhất là hình trụ thẳng hoặc cong, dài khoảng 5 cm 1 m, đường kính 1 10 cm. Vỏ ngoài màu vàng nâu, nhẵn, thể chất chắc. Mặt cắt ngang màu trắng ngà, không có xơ, nhiều bột. Rễ củ được cắt lát dày 0,3 0,7 cm, mặt ngoài màu trắng hoặc vàng nhạt, thể chất giòn và dễ vỡ, vết bẻ màu trắng, nhiều tinh bột. Hình 3.1. Ảnh chụp củ tươi (1a) và rễ củ Hoài sơn đã cắt lát, sấy khô (1b) Nhận xét: các chỉ tiêu trên phù hợp với tiêu chuẩn mô tả trong DĐVN V. 1a 1b
nâu
soi dướ


kính
th

y nhi
t tinh b
t hình tr
ng (1a) ho



c hình chuông (1b), có vân đồng tâm, rốn lệch tâm, hình chấm hoặc vạch. Tinh thể calci oxalat hình kim (2). Mảnh mô mềm gồm các tế bào màng mỏng, ch
tinh b
t (3). Mảnh mạch mạng (4).
DẠYKÈMQUYNHƠN OFFICIAL 32 3.2. KẾT QUẢ SOI BỘT Hình 3.2. Ảnh chụp đặc điểm bột rễ củ Hoài sơn Bột màu
,
i
hiển vi
ấ
ều hạ
ộ
ứ
ặ
ứa
ộ
Nhận xét: Các chỉ tiêu trên phù hợp với mô tả trong DĐVN V. 3.3. KẾT QUẢ ĐỊNH TÍNH 3.3.1. Hiện tượng huỳnh quang Tiến hành làm thử nghiệm như mục 2.2.3.1. Kết quả cho thấy bột dược liệu phát quang màu trắng sáng dưới ánh sáng tử ngoại. Hình 3.3. Ảnh chụp bột Hoài sơn soi dưới ánh sáng tử ngoại ở bước sóng 366 nm 1a 2 3 1b 4

DẠYKÈMQUYNHƠN OFFICIAL 33 3.3.2. Sắc ký lớp mỏng Tiến hành thử nghiệm như mục 2.2.3.2. Trên bản mỏng sắc ký mẫu dung dịch thử và dung dịch đối chiếu cho các vết màu như mô tả bảng 3.1. Bảng 3.1. Rf và màu sắc của các vết trên sắc ký đồ mẫu dịch chiết đối chiếu và dịch chiết thử bột Hoài sơn Vết Màu sắc Rf 1 Hồng 0,16 2 Xám đen 0,31 3 Hồng nhạt 0,37 4 Xám tro 0,43 5 Xám 0,64 Hình 3.4. Ảnh chụp các vết trên bản mỏng sắc ký mẫu dịch chiết đối chiếu và dịch chiết thử bột Hoài sơn Nhận xét: dung dịch thử có các vết cùng màu và giá trị Rf với dung dịch đối chiếu trên sắc ký đồ 5 vết tách nhau và hiện màu rõ theo thứ tự như mô tả trong bảng 3.1.
DẠYKÈMQUYNHƠN OFFICIAL 34 3.4. KẾT QUẢ XÁC ĐỊNH ĐỘ ẨM Tiến hành xác định độ ẩm theo phương pháp mất khối lượng do làm khô của DĐVN V, phụ lục 9.6. Cách tiến hành như mục 2.2.4. Kết quả được trình bày ở bảng 3.2. Bảng 3.2. Độ ẩm của rễ củ Hoài sơn Mẫu Khối lượng mẫu thử (g) Độ ẩm (%) 1 1,0012 12,05 2 1,0006 12,09 3 1,0007 11,94 X ± SD 12,03 ± 0,06 RSD (%) 0,53 Nhận xét: độ ẩm của mẫu nghiên cứu khoảng 12,03%. Kết quả này phù hợp với mức độ ẩm được áp dụng đối với dược liệu quy định trong DĐVN V là không quá 14%. 3.5. KẾT QUẢ TRO TOÀN PHẦN Tiến hành xác định tro toàn phần như mục 2.2.5. Kết quả được trình bày ở bảng 3.3. Bảng 3.3. Tro toàn phần của rễ củ Hoài sơn Mẫu Khối lượng mẫu thử (g) Tro toàn phần (%) 1 2,0007 3,47 2 2,0011 3,32 3 2,0023 3,51 X ± SD 3,43 ± 0,13 RSD (%) 3,79
DẠYKÈMQUYNHƠN OFFICIAL 35 Nhận xét: tro toàn phần của mẫu nghiên cứu khoảng 3,43%. Kết quả này phù hợp với mức tro toàn phần được áp dụng đối với dược liệu quy định trong DĐVN V là không quá 4%. 3.6. KẾT QUẢ XÁC ĐỊNH TẠP CHẤT 3.6.1. Dược liệu có màu vàng và đỏ Kiểm tra bằng cảm quan cho thấy, không có dược liệu màu vàng và đỏ trong rễ củ Hoài sơn đã làm khô. 3.6.2. Tạp chất Tiến hành thử nghiệm như mục 2.2.6.2. Kết quả được trình bày ở bảng 3.4 Bảng 3.4. Tạp chất trong rễ củ Hoài sơn Mẫu Khối lượng mẫu thử (g) Tạp chất (%) 1 50,13 0,43 2 50,07 0,42 3 50,03 0,43 X ± SD 0,43 ± 0,01 RSD (%) 1,35 Nhận xét: lượng tạp chất trong dược liệu khoảng 0,43% nằm trong giới hạn tạp chất cho phép theo quy định của DĐVN V đối với Hoài sơn là không quá 0,5%. 3.7 KẾT QUẢ XÁC ĐỊNH CÁC CHẤT CHIẾT ĐƯỢC TRONG DƯỢC LIỆU 3.7.1. Chất chiết được trong nước Tiến hành thử nghiệm như mục 2.2.7.1. Kết quả được trình bày ở bảng 3.5.
DẠYKÈMQUYNHƠN OFFICIAL 36 Bảng 3.5. Chất chiết được trong rễ củ Hoài sơn bằng nước Mẫu Khối lượng mẫu thử (g) Lượng chất chiết được trong nước (%) 1 4,0093 9,82 2 4,0017 10,01 3 4,0003 9,77 X ± SD 9,87 ± 0,13 RSD (%) 1,31 Nhận xét: lượng chất chiết được trong rễ củ Hoài sơn bằng nước khoảng 9,87%. Kết quả này phù hợp lượng chất chiết được trong nước áp dụng đối dược liệu theo quy định của DĐVN V là không ít hơn 5% tính theo dược liệu khô kiệt. 3.7.2. Chất chiết được trong cồn Tiến hành thử nghiệm như mục 2.2.7.2. Kết quả được trình bày ở bảng 3.6. Bảng 3.6. Chất chiết được trong rễ củ Hoài sơn bằng cồn Mẫu Khối lượng mẫu thử (g) Lượng chất chiết được trong cồn (%) 1 4,0130 7,56 2 4,0020 7,41 3 4,0020 7,29 X ± SD 7,42 ± 0,13 RSD (%) 1,75
DẠYKÈMQUYNHƠN OFFICIAL 37 Nhận xét: lượng chất chiết được trong rễ củ Hoài sơn bằng cồn khoảng 7,42%. Kết quả này phù hợp lượng chất chiết được trong cồn áp dụng đối với dược liệu theo quy định của DĐVN V là ít hơn 4% tính theo dược liệu khô kiệt. 3.8. KẾT QUẢ ĐỊNH LƯỢNG ALLANTOIN BẰNG SẮC KÝ LỎNG HIỆU NĂNG CAO 3.8.1. Kết quả thẩm định phương pháp định lượng 3.8.1.1. Tính tương thích hệ thống Tiêm 6 lần dung dịch chuẩn allantoin nồng độ 12,5 µg/ml vào hệ thống HPLC, tiếnhànhsắc kýtheo điềukiệnđã xâydựng. Kết quả khảo sát tínhtương thích của hệ thống sắc ký được trình bày trong bảng 3.7. Bảng 3.7. Kết quả khảo sát tính tương thích hệ thống sắc ký STT Thời gian lưu (phút) Diện tích pic (µV*s) Hệ số bất đối Số đĩa lý thuyết (N) 1 9,420 1460869 1,239 11671 2 9,453 1472649 1,250 11984 3 9,420 1472713 1,242 11716 4 9,420 1458535 1,206 11765 5 9,460 1484282 1,254 11876 6 9,400 1417509 1,219 11555 X ± SD 9,429 ± 0,023 1461093 ± 23291 1,235 ± 0,019 11761 ± 152,0 RSD (%) 0,243 1,738 1,514 1,292

DẠYKÈMQUYNHƠN OFFICIAL 38 Nhận xét: kết quả khảo sát cho thấy RSD (%) diện tích pic của allantoin, số đĩa lý thuyết, hệ số bất đối trong 6 phép thử đều nằm trong khoảng cho phép (< 2%), các giá trị của thời gian lưu cũng nằm trong giới hạn < 1%. Điều này chứng tỏ hệ thống được sử dụng là phù hợp và đảm bảo ổn định cho phép phân tích định lượng allantoin 3.8.1.2. Độ đặc hiệu chọn lọc Kết quả khảo sát độ đặc hiệu được thể hiện bằng hình ảnh sắc ký đồ của mẫu trắng, dung dịch chuẩn và dung dịch thử như hình 3.5, hình 3.6 và hình 3.7. Hình 3.5. Sắc ký đồ mẫu trắng


DẠYKÈMQUYNHƠN OFFICIAL 39 Hình 3.6. Sắc ký đồ dung dịch chuẩn allantoin nồng độ 12,5 µg/ml Hình 3.7. Sắc ký đồ dung dịch thử Nhận xét: trên sắc ký đồ của dung dịch chuẩn và dung dịch thử chứa allantoin đều cho 1 pic ở khoảng thời gian 9,4 phút và trên sắc ký đồ mẫu trắng không xuất hiện pic trong khoảng thời gian tương ứng với thời gian lưu của allantoin. Điều này chứng tỏ phương pháp lựa chọn là đặc hiệu cho phân tích định lượng allantoin.
DẠYKÈMQUYNHƠN OFFICIAL 40 3.8.1.3. Khoảng tuyến tính Kết quả khảo sát sự phụ thuộc tuyến tính giữa nồng độ và diện tích pic của allantoin trong khoảng nồng độ từ 12,5 µg/ml đến 125,0 µg/ml. Khối lượng cân chất chuẩn allantoin 5,3 mg. Bảng 3.8. Sự tương quan giữa diện tích pic và nồng độ allantoin STT Nồng độ (µg/ml) Diện tích pic (µV*s) Nồng độ theo đường chuẩn (µg/ml) Độ chệch ∆i (%) 1 13,05 1460869 12,85 1,55 2 26,01 2899382 26,15 0,53 3 52,21 5910281 53,99 3,41 4 78,31 8566229 78,55 0,30 5 104,41 10774083 98,96 5,22 6 130,51 14564589 134,01 2,68
DẠYKÈMQUYNHƠN OFFICIAL 41 Hình 3.8. Đồ thị biểu diễn sự phụ thuộc tuyến tính giữa nồng độ và diện tích pic của allantoin Nhận xét: trong khoảng nồng độ khảo sát (12,5 125,0 µg/ml) có sự phụ thuộc tuyến tính chặt chẽ giữa diện tích pic và nồng độ chất cần định lượng. Phương trình hồi quy là y = 108151x + 71416 với hệ số R2 = 0,9957. Độ chệch các điểm nồng độ dùng xây dựng đường chuẩn không vượt quá ± 15%. Như vậy, đường chuẩn đã xây dựng đáp ứng yêu cầu của phép phân tích định lượng bằng HPLC. 3.8.1.4. Độ lặp lại Tiến hành phân tích dung dịch thử lặp lại 6 lần trong cùng 1 ngày với điều kiện sắc ký đã lựa chọn Kết quả được thể hiện ở bảng 3.9 y = 108151x + 71416 R² = 0.9957 0 2000000 4000000 6000000 8000000 10000000 12000000 14000000 16000000 0 20 40 60 80 100 120 140 Diện tích pic Nồng độ (µg/ml)
DẠYKÈMQUYNHƠN OFFICIAL 42 Bảng 3.9. Kết quả khảo sát độ lặp lại STT Khối lượng dược liệu (g) Diện tích pic (µV*s) Hàm lượng allantoin trong dược liệu (mg/g) 1 1,0008 6475745 6,73 2 1,0014 6605923 6,86 3 1,0007 6601122 6,86 4 1,0003 6550150 6,81 5 1,0011 6494867 6,74 6 1,0005 6501450 6,76 X ± SD 6,79 ± 0,06 RSD (%) 0,86% Nhận xét: kết quả thể hiện ở bảng 3.9 cho thấy giá trị của độ lặp lại trong ngày < 2%. Điều này chứng tỏ phương pháp đã chọn đảm bảo độ lặp của các thử nghiệm được thực hiện trong cùng một điều kiện và trong khoảng thời gian ngắn. 3.8.2. Kết quả định lượng allantoin trong Hoài sơn Trên cơ sở phương pháp đã lựa chọn, áp dụng để định lượng allantoin trong mẫu dược liệu rễ củ Hoài sơn. Kết quả định lượng allantoin trong rễ củ Hoài sơn được thể hiện ở bảng 3.10.
DẠYKÈMQUYNHƠN OFFICIAL 43 Bảng 3.10. Kết quả định lượng allantoin trong rễ củ Hoài sơn STT Khối lượng cân (g) Diện tích pic thử (µV*s) Hàm lượng (mg/g) 1 1,0008 6475745 6,73 2 1,0014 6605923 6,86 3 1,0007 6601122 6,86 X 6,82 Từ kết quả bảng 3.10, có thể kết luận lượng allantoin trong rễ củ Hoài sơn khoảng 6,82 mg/g tính theo dược liệu khô kiệt.
T LUẬN
t:
Bột rễ củ Hoài sơn có màu nâu, khi soi dưới kính hiển vi thấy: nhiều hạt tinh bột hình trứng hoặc hình chuông, có vân đồng tâm, rốn lệch tâm, hình ch
m
ch. Tinh th
calci oxalat hình kim. Mảnh mô mềm g
m các tế bào màng
DẠYKÈMQUYNHƠN OFFICIAL 44 KẾ
Đề tài đã đánh giá được một số chỉ tiêu chất lượng của dược liệu Hoài sơn (D. hamiltonii) như sau: * Mô tả: Rễ củ phình to, có nhiều hình dạng, phổ biến nhất là hình trụ thẳng hoặc cong, dài khoảng 5 cm 1 m, đường kính 1 10 cm. Vỏ ngoài màu vàng nâu, nhẵn, thể chất chắc. Mặt cắt ngang màu trắng ngà, không có xơ, nhiều bột. Rễ củ được cắt lát dày 0,3 0,7 cm, mặt ngoài màu trắng hoặc vàng nhạt, thể chất giòn và dễ vỡ, vết bẻ màu trắng, nhiều tinh bột. * Soi bộ
ấ
hoặc vạ
ể
ồ
mỏng, chứa tinh bột. Mảnh mạch mạng. * Định tính: Hiện tượng huỳnh quang Soi bột Hoài sơn dưới ánh sáng tử ngoại ở bước sóng 366 nm thấy phát quang màu trắng sáng. Sắc ký lớp mỏng Sắc ký lớp mỏng cho 5 vết dung dịch thử cùng màu và giá trị Rf với dung dịch đối chiếu trên sắc ký đồ. Các vết tách nhau và hiện rõ màu. * Độ ẩm Độ ẩm của mẫu Hoài sơn đem khảo sát là 12,03%. * Tro toàn phần Tro toàn phần của Hoài sơn là 3,43%. * Tạp chất Tạp chất chứa trong dược liệu Hoài sơn là 0,43%.
trong kho
Phương pháp
Hoài sơn định lượng đượ
trong ngày cao. Hàm lượ
là 6,82 mg/g tính theo
trong
DẠYKÈMQUYNHƠN OFFICIAL 45 * Lượng chất chiết được trong dược liệu Chất chiết được trong Hoài sơn bằng nước là 9,87% và chất chiết được trong Hoài sơn bằng cồn là 7,42%. * Định lượng allantoin bằng sắc ký lỏng hiệu năng cao Phương pháp lựa chọn có tương quan tuyến tính chặt chẽ giữa diện tích pic và nồng độ allantoin
ảng nồng độ khảo sát. Phương pháp có độ đặc hiệu cao với thời gian lưu của allantoin khoảng 9,4 phút, pic tách riêng biệt, rõ nét.
có độ lặp lại
ng allantoin
mẫu rễ củ
c
dược liệu khô kiệt.
DẠYKÈMQUYNHƠN OFFICIAL 46 KIẾN NGHỊ Do thời gian thực hiện đề tài có hạn nên những kết quả nghiên cứu trên của em mới chỉ đóng góp phần nào công trình nghiên cứu về cây Hoài sơn. Vì vậy, em xin đưa ra một số đề xuất sau: Ứng dụng các chỉ tiêu đã khảo sát để đánh giá chất lượng Hoài sơn. Tiếp tục khảo sát, tối ưu hóa các điều kiện sắc ký lỏng hiệu năng cao.
TÀI LIỆU THAM KHẢO
1. T. K. Lim (2016) Edible Medicinal and Non Medicinal Plants: Volume 10, Modified Stems, Roots, Bulbs (xu
th
2. Trương Thị
182 295.
3. ĐỗHuyBích,
QuangChung,
1). Springer, 261 - 265.
Chương
4. Viện Dượ
(2022) Trung tâm thông
http://vienduoclieu.org.vn/tttv/danh muc cay thuoc/cay thuoc/Dioscorea_persimilis_1576, truy cập ngày 25/05/2022.
Thư
5 Salehi B., Sener B., Kilic M. et al (2019) Dioscorea plants: A genus rich in vital nutra pharmaceuticals a review. Iranian Journal of Pharmaceutical Research: IJPR 18 (1): 68. DOI: 10.22037/ijpr.2019.112501.13795.
6. Đỗ Tất Lợi (2004) Những cây thuốc và vị thuốc Việt Nam (xuất bản lần thứ 7). NXB Y học, 848 850.
7. PubChem (2022) - National Library of Medicine. https://pubchem.ncbi.nlm.nih.gov/compound/204, truy cập ngày 23/07/2022.
et al (2016). Characterizing diversity based on
compositions of yam germplasm (Dioscorea spp.) commonly
Journal of food and
analysis 24(2): 367
Miao, J. et al (2019). Multicomponent analysis and activities
of Dioscorea oppositifolia and Dioscorea
DẠYKÈMQUYNHƠN OFFICIAL
ất bản lần
ứ
Đẹp (2007) Thực vật dược (xuất bản lần thứ 1). NXB Giáo dục,
Đặng
BùiXuân
và cs(2006) Cây thuốc và động vật làm thuốc ở Việt Nam Tập I (xuất bản lần thứ 2). NXB Khoa học và Kỹ thuật, 557 560.
c liệu
tin
viện.
8. Trần Thị Oanh, Nguyễn Thị Vân Anh (2014). Xác định hàm lượng Allantoin trong củ mài (Dioscorea persimilis Dioscoreaceae) bằng sắc ký lỏng hiệu năng cao. Nghiên cứu dược & Thông tin thuốc 3: 82 87.21. 9. Nguyễn Thị Hiền, Chu Thị Thu Hà, Hà Thị Vân Anh và cs (2015) Thành phần hóa học của Củ mài thu tại Mê Linh, Vĩnh Phúc. Tạp chí dược liệu 20 (1). 10. Wu Z. G., Jiang W., Nitin M.
nutritional and bioactive
cultivated in China.
drug
375. 11. 11Zhao, C., Zhou, B.,
for evaluation
hamiltonii. Food and Agricultural Immunology 30(1): 1148 - 1161. DOI: https://doi.org/10.1080/09540105.2019.1674786.
12. 12N. T. T. Nguyen., H. H. Nguyen, H. T. Nguyen et al (2020) Cytotoxic phenanthrenes and phenolic constituents from the tubers of Dioscorea persimilis. Phytochemistry Letters 40: 139 143. DOI: 10.1016/j.phytol.2020.10.005.
13. 13Archana P Raina, RC Misra (2019). Evaluation of diosgenin, a bioactive compound from natural source of Dioscorea species: A wild edible tuber plant. Journal of Pharmacognosy and Phytochemistry 2020 9(1): 1120 1124.
14. Nguyen Van Dan (1990) Medicinal Plants in Viet Nam (published for the first time). Science and Technology Publishing House, 146 - 147.
